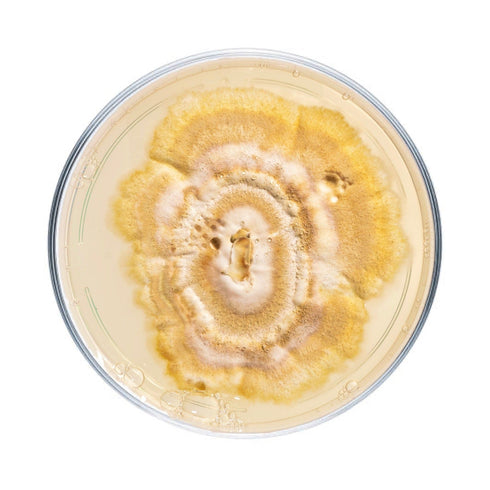

Reishi Mushroom Plate Culture

Species difficulty | Advanced |
Culture format | Agar plate |
Lab skills | Intermediate |
Shelf life | 6 months (refrigerated) |
Plate cultures are ideal for growers looking to make master bags, inoculate grain, make liquid culture, or make more plates.
Our reishi plates are made to order in our in-house lab using medical-grade petri dishes. If properly stored upon arrival, they have a shelf life of approximately 6 months. Reishi plates should be stored in the refrigerator to maintain viability. Note that mycelium cultures require basic lab skills. Handle using sterile technique to prevent contamination.
For complete descriptions of available reishi strains, click on the names below.
-
Ganoderma lucidum. Our favorite indoor Reishi strain. Produces dense and colorful antlers when grown indoors in bags. Best grown using filter patch bags with minimal air exchange.
-
Ganoderma tsugae. This mushroom is found almost exclusively on the wood of eastern hemlocks. Has a distinct, shiny appearance and is often called "hemlock varnish shelf."